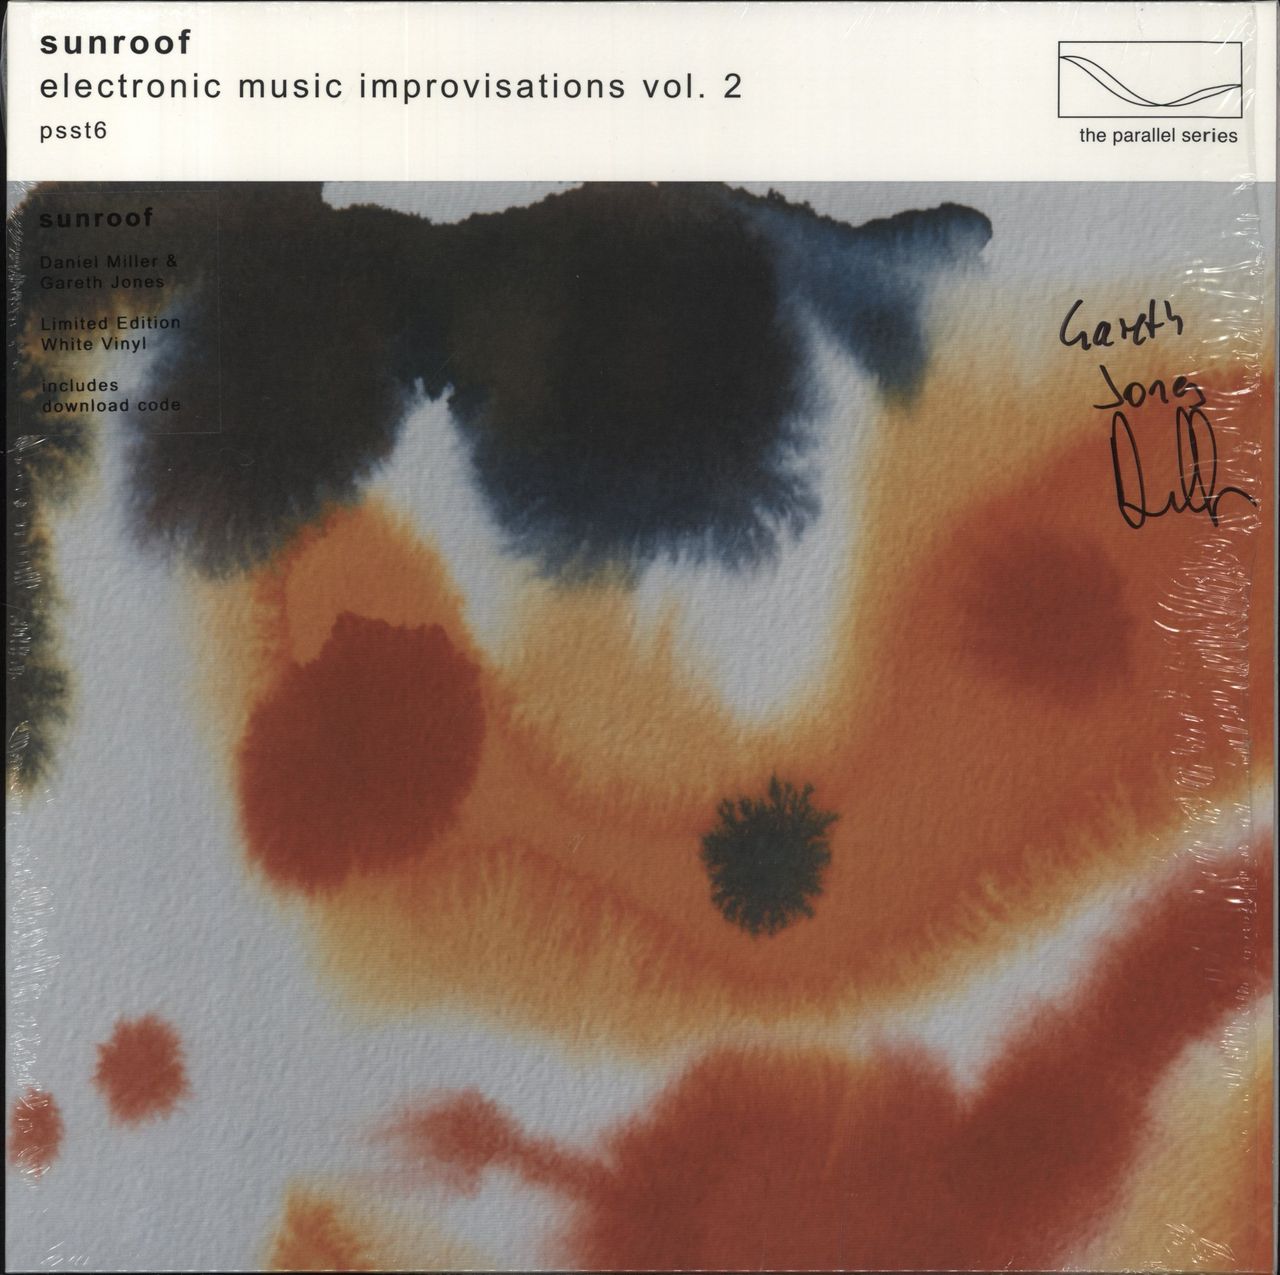

Description
Product code:
Sunroof – Electronic Music Improvisations Vol. 2, Limited Edition White Vinyl LPTop Find Hayroe's Marvel Baking Powder Tin (JL)Limited Find retail,Great Buy Heliod God of the Sun 1x FOIL THS MTG Theros Mythic MINT whiteAmazing Price retail,Special Offer Janod Soup SetSpecial Save retail,Best Value Rita Earrings in AquamarinaBest Mega retail,Hot Offer FISH & KIDS ECRU “F” PATCH OVERSIZED SWEATSHIRTHot Mega retail,Best Find 14k Yellow Gold Wing In Heart PendantAmazing Price retail,Save Now Paparazzi "Beautiful Bravado" Blue BraceletLimited Pick retail,Mega Save WESTBRASS Satin Nickel Bathtub Spout with DiverterHot Sale retail,Quick Deal Paparazzi "Royal Roulette" White Hair ClipTop Mega retail,Quick Deal -4AN to 8mm x 1.25 Metric Straight Adapter 16603Hot Value retail,Quick Deal casual Stripe high waist maxi skirtsFlash Choice retail,Quick Sale Energy Suspension Front Cont Arm Bushing Set GM 3.3102GHot Sale retail,Best Grab Uriage Baby's 1st Soothing Cradle Cap Care Regulating Cream 40mlHot Buy retail,Best Find Drake Muscle Cars Leaf Spring 4 Leafs 64-73 MustangGreat Super retail,Big Savings Wilwood Front Brake KitLimited Stock retail,Mega Price Long Sleeves Lace A-line Wedding Dresses, Popular Elegant Wedding DressesLimited Find retail,Must Buy Abolos Metro 80-Pack Celery Green/Glossy 3-in x 6-in Glossy Glass Subway Wall TileLimited Pick retail,Limited Time Paparazzi "Noble Nature" Blue BraceletSuper Grab retail,Quick Grab Workshop ElfBest Top retail,Hot Pick Native American Christin Wolf Lapis Sterling Silver RingFlash Pick retail,Top Find Klotz Pure Estorlin Gear Oil 75w110Super Find retail,Great Grab QuickCar Extreme 3-1 OP/WT/FP w/3" TachHot Value retail,Save Now A Mid-Century Stained Oak Open Arm Armchair Attributed to Jean PascaudSuper Sale retail,Super Value Moroso Ultra Plug Wire Set SBC Under Valve Cover BlackHot Super retail,Best Value The Real Parts Of The Boat - Funny Rowing T ShirtTop Choice retail,Great Deal Allstar Reducer NPT 1/2in to 1/4inGreat Choice retail,Top Price Apna Time Ayega TshirtLimited Buy retail,Hot Savings Sterling Silver Diamond And Garnet or Peridot Cushion Square PendantSpecial Save retail,Super Buy HC-182 Classic BurgundyTop Choice retail,Flash Offer Ball Hat with Neck Flap - PinkTop Offer